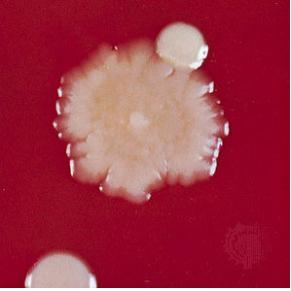

섬유질배합사료를 일반적으로 그냥 배합비율에 의하여 믹싱하는 TMR(Total Mixed Ration)과 TMR과정
에 발효과정을 가미한 TMF(Total Mixed Fermentation), 곡물과 조사료가 모두 배합 된다고 하여
CMR(Complete Mixed Ration)이라고 하며, 곡물사료는 따로 급여하고 일부분 배합한다는 의미를
부여하여 SMR(Semi- Mixed Ration)이라고 칭하는 경우의 학자도 있습니다.
섬유질배합사료의 변천과정에서 현재(2011년)에는 4위동물의 1위의 소화흡수율을 높여 생산성을
높이기 위하여 발효를 하여 급여한다는 TMF가 보편화 되어가고 정착화 되어가고 있다.
초식가축의 섬유질배합사료 제조과정에 사용되는 발효(fermentation)에 대하여 농가나 자가배합
농가가 알아야 할 기초내용을 기술합니다.
TMF에서의 발효란 ..?
대가축(한우,젖소등 4위동물)에게 급여하는 섬유질배합사료의 이용율을 높이기 위해 배합된 모든
사료(알곡사료+조사료+부산물...)에 발효균주를 인위적으로 투입하여 원료가 가지고 있는 당(糖)을
분해하는 균주를 최대한 활성화 시켜주는 것이라고 정의 할 수 있다,
발효균을 준비하고 투입하는 과정에서 섬유질에 포함되어 있는 다당류, 단당류를 분해하는데 균주
들이 왕성하게 살수 있는 조건을 만들어 주는 것이 관건이다.
즉 비싼 단미사료라고 균주들이 잘 살아간다고 할 수 없으며, 저가의 조악한 사료원료라도 어떠한
균주에는 적합할 수가 있는 것이다. 균주들이 왕성한 분해작용을 하며 살아 갈 수 있도록 좋아하는
원료를 주고 조건을 만들어 주는 기술 습득이 TMF의 성공이다.
사료분야에서 주로 사용되는 균주는
① yeast(효모) ② Lactobacillus(유산균) ③ Bacillus(간균) ④ Aspergillus(누룩곰팡이)
등이 사용되며, 호기성, 혐기성 상태에서 발효균주들은 섬유질배합사료 속에 들어있는 먹이감들을
이용하여 자기증식을 해나가는 것이 발효라고 할 수 있다.
※ 1g당에 포함되어 있는 균수로 표시하는 것이 정상 (103...10.7 ..1010....)
일부업체에서는 1kg 라고 표기하는 우를 범하는 업체가 있듯이 균수에 대한 정확한 내용을 모르고
영업하는 회사도 있다.
★ 아래의 내용들을 참조하여 보시기 바랍니다.
발효 [fermentation, 醱酵]란..?
효모(酵母)ㆍ박테리아와 같은 미생물(微生物)에 의(依)해서 유기(有機) 화합물(化合物)이 분해(分解) 산화(酸化)ㆍ환원(還元)하여 주정류ㆍ유기산류(有機酸類)ㆍ탄산(炭酸) 가스 등(等)을 생기게 하는 작용(作用). 술ㆍ간장ㆍ초ㆍ된장 등(等)의 제조(製造)에 이용(利用)함.
효모나 세균 따위의 미생물이 유기 화합물을 분해하여 알코올류, 유기산류, 탄산가스 따위를 생기게 하는 작용. 좁은 뜻으로는 산소가 없는 상태에서 미생물이 탄수화물을 분해하여 에너지를 얻는 작용을 이른다. 술, 된장, 간장, 치즈 따위를 만드는 데에 쓴다. 최소한 1만 년 전부터 알려져온 과정으로, 원래는 포도주와 맥주의 제조과정에서 생기는 기포(氣泡)를 가리키는 말.
이러한 기포 발생이 이산화탄소 때문이라는 것이 밝혀진 것은 17세기였다. 19세기에 루이 파스퇴르는 공기가 없는 혐기성(嫌氣性) 상태에서 사는 미생물들과 효모에 의한 화학변화를 설명하기 위해 좁은 의미에서 이 용어를 사용했다. 그는 또한 에틸알코올과 이산화탄소 외에도 다른 발효 생성물이 있음을 밝혀냈다. 1920년대에 공기가 없는 상태에서 근육의 추출물이 포도당(글루코오스)으로부터 젖산염(락트산염)의 형성을 촉진한다는 사실과, 곡물의 발효과정에서 생성되는 중간물질인 젖산염이 근육에서도 생성된다는 사실이 알려졌다. 발효반응은 효모 특유의 작용에 의해서뿐 아니라 포도당을 이용하는 다른 많은 경우에도 일어난다는 중요한 사실이 확립되었다.
해당과정(解糖過程)은 보통 당이 분해되는 것을 의미하는데, 1930년 무렵에는 당으로부터 젖산염이 분리되는 과정이라고 정의되었다. 또한 일반적으로 육탄 당인 포도당이 2분자의 피루브산으로 바뀌는 특정 형태의 발효로 정의되기도 한다. 3개의 탄소원자로 이루어진 유기산(有機酸)인 이 피루브산은 이온화하여 피루브산염을 형성하기도 하며, 아데노신삼인산(ATP)의 합성에 관여해 화학 에너지 전달과정에 작용하기도 한다. 포도당으로부터 형성된 피루브산은 그 다음 과정에서 피루브산염을 형성해, TCA 회로를 거치는 동안 산소가 있으면 완전히 산화되고, 산소가 없는 또다른 과정을 통해서는 젖산·알코올 또는 다른 생성물들로 환원된다. 포도당으로부터 피루브산염까지의 일련의 과정을 흔히 2명의 독일 생화학자의 이름을 따서 엠프덴-마이어호프 경로라 한다. 이 두 사람은 1920년대 후반과 1930년대에 이러한 일련의 반응에는 중요한 단계들이 존재한다고 가정하고 이를 실험적으로 분석했다.
오늘날 발효라는 용어는 포도당같이 에너지를 내는 분자들이 혐기성 상태에서 효소에 의해 분해가 촉진되어 에너지가 생성되는 과정을 의미한다. 대부분의 세포에 그러한 효소가 있고, 특히 세포질의 가용성 부분에 존재한다. 그리하여 피루브산염을 형성하는 반응들은 근육, 효모, 몇몇 세균 및 식물계에서 일어나는 당변환의 일반적인 형태이며, 이 과정에서 생성되는 화합물 중의 하나는 에너지가 풍부하게 저장되어 있는 ATP이다. 또다른 생성물인 피루브산염은 세포 형태와 산소의 이용도에 따라 여러 가지로 변환할 수 있다. 공업적 발효과정은 적당한 미생물과 특정 조건, 즉 영양분의 농도를 적당하게 조절함으로써 시작된다. 여러 형태의 생성물은 다음과 같다. 여러 가지 당이 효모에 의해 발효되어서 얻어진 알코올·글리세롤·이산화탄소와, 여러 종류의 세균으로부터 얻는 부틸알코올·아세톤·젖산·글루탐산나트륨·아세트산, 또 곰팡이균에 의해 발효가 되는 구연산·글루콘산 및 소량의 항생물질, 비타민 B12 및 리보플라빈(비타민 B2) 등이 있다.
1. monosaccharide [단당류, 單糖類]
탄수화물의 기초단위가 되는 화합물.
중성의 결정성 물질로 약간 단맛이 나는, 더 이상 간단한 분자로 가수분해되지 않는 탄수화물. 가수분해에 의해서 그 이상 작은 분자로 분해되지 않는 당질의 기본 단위.
단당류는 다가(多價)의 히드록시기를 갖는 알데히드 또는 케톤에 해당하는 것으로 1개 이상의 히드록시기(-OH)를 가지며, 말단(末端) 탄소원자(알도오스) 또는 2번째 탄소원자(케토오스)에 카르보닐기(C=O)를 갖는 분자이다. 수용액에서 카르보닐기는 1개의 히드록시기와 결합하여 고리형 화합물(헤미-아세탈 또는 헤미-케탈)을 생성한다. 단당류는 분자 내의 탄소수에 따라 다음과 같이 분류된다. 탄소수가 3인 것은 트리오스, 4인 것은 테트로오스, 5인 것은 펜토오스, 6인 헥소오스 및 7은 헵토오스라 한다. 탄소수가 5인 것과 6인 것이 가장 많다. 가장 중요한 펜토오스는 목재 크실란의 구성단위로 알려져 있는 크실로오스, 침엽수로부터 얻어지는 아라비노오스, 리보핵산 및 여러 가지 비타민류의 구성성분인 리보오스 및 디옥시리보핵산의 구성성분인 디옥시리보오스가 있다. 중요한 알도헥소오스 중에는 포도당·만노오스·갈락토오스가 있으며, 케토헥소오스로는 과당이 있다.
여러 가지 중요한 단당류 유도체들도 있다. 아스코르브산(비타민 C)은 포도당으로부터 생성된다. 단당류의 환원, 즉 단당류에 수소첨가에 의해 생성된 중요한 당알코올류(알디톨)에는 포도당을 환원해서 만든, 솔비톨(글루시톨)과 만노오스로부터의 만니톨이 있으며, 둘다 감미제(甘味劑)로 사용된다. 단당류에서 유도되는 글리코시드는 천연에 널리 퍼져 있으며, 특히 식물류에 풍부하다. 아미노당류(1~2개의 히드록시기가 아미노기[-NH2]로 치환된 당)는 당지질(糖脂質)과 절지동물의 키틴의 구성성분으로 알려져 있다.
2. polysaccharide [다당류, 多糖類]
글리칸이라고도 함.
대부분의 천연 탄수화물이 가지는 형태.
2개 이상의 단당류가 글리코시드 결합에 의하여 탈수, 축합되어 만들어지는 분자량이 큰 탄수화물. 단당류가 글리코시드 결합으로 중합한 고분자화합물의 총칭.
다당류는 가지를 가지거나 혹은 선형인 분자구조를 가진다. 셀룰로오스와 같은 선형 화합물들은 서로 조밀하게 종종 단단한 구조를 형성하고, 가지를 가진 형태는 일반적으로 물에 녹아서 반죽 상태의 용액을 만든다.
한 종류의 당 또는 당 유도체의 분자들로만 구성된 다당류를 호모 다당류(혹은 호모글리칸)라 한다. 포도당으로 구성된 호모 다당류로 동물과 식물의 탄수화물의 각각의 저장형태인 글리코겐과 녹말 및 대부분의 식물에서 나타나는 중요한 구조성분인 셀룰로오스 가 있다. 특정 세균에 의해 점액형태로 분비되며, 포도당으로 구성된 호모 다당류인 덱스트린은 쇼크를 치료할 때 혈장(血漿)의 대체물질로 사용한다.
그외 다른 호모 다당류는 목재·견과(堅果) 그리고 다른 식물의 생성물로부터 얻어지는 아라비노스 혹은 크실로오스로 구성된 펜토산과 예루살렘 아티초크와 다알리아의 뿌리와 괴경(塊莖)으로부터 얻어지는 이눌린과 같이 과당(프룩토오스)으로 구성된 프룩탄이 포함된다. 만노오스로 구성된 호모 다당류는 상아야자 나무열매, 난초의 괴경, 소나무류, 균류(菌類), 세균에 존재한다. 과실과 장과(漿果)에서 발견되며, 상업적으로 겔화제로 사용하고 있는 펙틴은 갈락토오스당의 유도체인 갈락투론산의 유도체로 구성된다. 절지동물(곤충 및 갑각류)의 겉껍질 골격은 키틴으로 구성되어 있으며, 키틴의 반복단위는 포도당에서 유도되는 물질인 N-아세틸-D-글루코사민이다. 게와 바다가재와 같은 절지동물의 껍질은 약 25%의 키틴을 함유한다. 키틴은 환형벌레·연체동물·해파리·이끼벌레류·선충류(線蟲類) 등 무척추동물들의 특정 구조에서도 발견된다. 키틴은 대부분의 균류의 세포벽에도 존재한다. 천연에서 키틴은 단백질과 결합되어 있다.
여러 종류의 당 또는 당유도체로 구성된 다당류는 헤테로 다당류(헤테로글리칸)라 한다. 대부분은 2개의 다른 단위구조로 구성되며, 혈장의 감마 글로불린 및 산성의 뮤코 다당류와 같은 당단백질이나 중추신경계의 강글리오시드와 같은 당지질과 연관되어 있다. 산성의 뮤코 다당류는 동물조직에 널리 분포되어 있고, 기본단위는 N-아세틸-D-글루코사민에 연결된 글루쿠론산으로 구성된 혼합이당류이다. 결합조직에 존재하는 히알루론산 같은 천연에 풍부한 뮤코 다당류는 또한 관절활액(滑液)의 중요한 구성성분이며, 포유동물의 탯줄의 결합조직에서도 나타난다. N-아세틸-D-갈락토사민과 연결된 글루쿠론산은 또한 연골조직에서 발견되는 헤테로 다당류인 연골질황산염의 반복단위이다. 산성의 뮤코 다당과 관련된 헤테로 다당류인 헤파린은 응고를 방해하는 성질이 있으며, 결합조직 및 다른 조직에 존재한다.
아카시아로부터 얻은 아라비아 고무와 자운영에서 얻어지는 트래거캔스 고무와 같은 식물성 고무에서 다소 복잡한 헤테로 다당류가 나타난다. 이 형태의 대부분의 당류는 글루쿠론산과 함께 여러 가지 당을 포함하고 있다. 식물성 고무는 나무껍질에 기계적인 손상(상업적 생산수단으로 이용되는 방법)을 주거나, 세균·곤충 혹은 균을 침투시켜 생산되며, 미술 재료(아라비아 고무)로 사용되거나 접착제 및 유화제(乳化劑)로 쓰인다. 헤테로 다당류는 또한 세균의 세포벽에서도 존재한다.
3. 탄수화물 [carbohydrate, 炭水化物]
당류·녹말·셀룰로오스를 포함하는 매우 풍부하고 광범위한 천연 유기물질.
19세기초에 최초로 탄수화물을 분석해 물(H2O)에서 발견되는 것과 같은 비율의 수소(H)와 산소(O) 및 탄소(C)로 구성되어 있다는 것이 밝혀졌다. 탄수화물의 일반식은 Cn(H2O)m이나 그 부류가 너무 광범위해 간단한 정의로 이들을 모두 망라하지 못한다.
탄수화물에 대한 몇 가지 분류체계 가운데 가장 흔히 쓰이는 것 중의 하나는 탄수화물을 단당류·이당류·올리고당류·다당류로 나누는 것이다. 단당류 분자는 3~9개의 탄소원자를 가지고 있는데, 대부분은 5개나 6개를 가지고 있다. 가장 중요한 단당류로는 포도당(글루코오스:덱스트로오스 또는 옥수수당이라고도 함)·프룩토오스(과당)·갈락토오스 등이 있다. 이당류는 2개의 간단한 당분자가 서로 연결되어 있다. 이당류인 수크로오스(설탕)는 포도당 1분자와 프룩토오스 분자로 되어 있다. 락토오스(젖당)와 말토오스도 이당류이다. 3~6개의 단당류 단위로 이루어진 올리고당류는 드물다.
다당류는 셀룰로오스·녹말·글리코겐 같은 커다란 분자로 1만 개 이상의 단당류 단위가 서로 연결되어 있다. 다당류에는 천연에서 발견되는 대부분의 구조 탄수화물과 저장 탄수화물이 포함되어 있다. 녹색식물은 이산화탄소와 물을 탄수화물로 전환하기 위해 광합성을 한다. 광합성 과정에서는 산소가 대기 중으로 방출되고 빛 에너지가 탄수화물의 화학 에너지로 바뀐다. 식물은 간단한 탄수화물을 여러 과일에 들어 있는 수크로오스, 식물의 주요구조성분인 셀룰로오스, 저장 녹말, 그리고 필수 구조성분으로 작용하는 매우 다양한 그밖의 다당류로 전환한다.
대부분의 동물에서 탄수화물은 빨리 이용할 수 있는 에너지 저장원으로 작용한다. 포도당은 고등동물의 혈액 내에서 순환하는 당으로 세포에 의해 흡수, 산화되어 대사과정에 필요한 에너지를 제공한다. 글리코겐은 포도당 분자가 가지난 사슬형태로 고등동물의 간과 근육에 저장되어, 스트레스를 받거나 근육활동이 일어나면 포도당으로 분해된다. 다당류는 특정 동물의 구조성분으로 작용한다. 예를 들어 셀룰로오스와 비슷한 키틴질은 곤충과 다른 절지동물의 외골격을 만든다.
단당류의 명명법은 분자 내 탄소원자의 수를 나타내는 접두어(예를 들면 pent-는 5, hex-는 6)와 접미사인 오스(ose)가 결합된 것이다. 그러므로 '펜토오스'는 5개의 탄소원자를 가지고 있는 단당류를 가리킨다. 단당류 분자가 곧은 사슬 형태를 가진다면 그것의 탄소원자가 분자의 뼈대를 형성하여 사슬 말단에 있는 탄소원자에 대개 히드록시기(OH)나 1개의 수소 원자가 결합된다. 히드록시기로 인해 물에 대한 당의 용해도가 커진다.
어떤 탄소들은 산소와 이중결합을 하여 다른 탄소와는 다른 형태로 존재하며 사슬 중간에 있는 탄소원자와 산소가 이중결합을 하면 케톤기, 사슬의 말단 탄소원자와 산소가 이중결합을 하면 알데히드기가 된다. 따라서 단당류는 알데히드와 케톤이며, 'aldo-'·'keto-'의 접두사로 나타낸다. 예를 들면 알도펜토오스(aldopentose)와 케토헥소오스(ketohexose)가 있다. 6개의 탄소원자와 하나의 알데히드기를 가지고 있는 포도당은 알도헥소오스이다. 많은 탄수화물은 이성질체(異性質體:원자 조성은 같지만 구조는 다름)이다. 예를 들어 포도당·프룩토오스·갈락토오스는 모두 화학식이 C6H12O6인 이성질체이다(→ 색인 : 이성질).
천연에서 가장 흔하게 산출되는 단당류인 헥토오스에는 포도당·만노오스·프룩토오스가 펜토오스에는 크실로오스·아라비노오스가 있다. 2개의 다른 단당류인 리보오스와 디옥시리보오스는 모든 세포에서 발견되는데, 여기서 이들은 각각 리보핵산(RNA)과 디옥시리보핵산(DNA)의 탄수화물 성분을 형성한다. 크실로오스는 목화씨 껍질, 옥수수 속대, 밀짚을 원료로 하여, 그 속에 들어 있는 다당류인 크실란을 화학분해해서 제조한다. 갈락토오스는 한천과 카라기닌 같은 올리고당류와 다당류의 공통 성분으로 대부분의 동물의 뇌와 신경조직에 들어 있는 당지질(탄수화물을 포함하고 있는 지질)에서 산출된다.
갈락토오스는 일반적으로 갈락토오스와 포도당으로 구성되어 있는 이당류인 락토오스에서 만들어진다. 포도당은 과일·꿀·혈액과 비정상 조건하의 요(尿)에서 발견된다. 그것은 또 천연에서 가장 흔히 산출되는 2개의 이당류인 수크로오스와 락토오스의 성분이며, 다당류인 셀룰로오스·녹말·글리코겐의 유일한 구조 단위이다. 포도당은 상업적으로 옥수수 녹말을 가수분해하여 대량생산되며 대부분은 옥수수 시럽으로 팔리고 결정 형태는 때로 덱스트로오스라는 이름으로 팔린다. 프룩토오스는 이당류인 수크로오스 성분의 하나로 꿀·사과·토마토에 결합되지 않은 형태로도 존재하지만 대부분은 수크로오스에서 얻어지며, 식품공업에 사용된다. 아라비노오스는 식물성 고무(이 이름은 아라비아 고무에서 유래)에서 얻어지며, 펙틴의 성분이다. 만노오스는 만난이라는 다당류에서 얻을 수 있다.
대부분의 단당류는 쉽게 산화될 수 있다. 이 반응은 오랫동안 혈액과 요의 포도당을 검출하는 데 사용되었다(혈액과 尿는 포도당 산화효소라는 효소로 분석하는데, 이 효소는 포도당의 산화반응의 촉매로 작용해 과산화수소를 포함하는 생성물을 형성하고, 이 과산화수소가 반응혼합물 속에 들어 있는 염료를 산화시킴). 어떤 단당류의 말단기(末端基)가 화학적·생물학적으로 산화되면 우론산이 형성된다. 포도당으로부터 형성되는 글루쿠론산은 결합조직에 존재하는 다당류의 주요성분이다. 글루쿠론산을 비롯한 우론산들은 요로 배설된다.
당류는 수소의 첨가에 의해 알디톨, 즉 당알코올로 환원된다. 글루코오스로부터 형성된 생성물은 소르비톨로 보통 감미제로 사용된다. 만노오스는 환원되어 만니톨을 만드는데, 이것도 감미료로 사용된다. 세포를 포함하고 있는 용액 내의 당은 고리구조를 이루며, 이 구조 안의 히드록시기가 탄소에 붙어 알데히드기와 케톤기를 만드는 것으로 추측된다. 이 히드록시기는 매우 반응성이 뛰어나 당끼리 반응하게 하거나 다른 화합물과 반응하여 글리코시드라고 하는 유도체를 형성한다. 천연 글리코시드는 식물염료(인디칸), 심근자극제(디기탈리스), 항생제(스트렙토마이신), 향료의 원료(바닐린) 등으로 널리 이용된다.
단당류에서 생성되는 화합물 중 히드록시기가 아미노기(NH2)로 치환된 것을 아미노당이라고 하며 천연에 널리 분포되어 있다. 디옥시당은 하나의 히드록시기가 수소원자로 치환된 것이다. 이 중에서 가장 중요한 것은 리보오스에서 유도된 디옥시리보오스로 유전정보를 전달하는 디옥시리보핵산(DNA)에 존재한다. 이당류는 특수한 글리코시드로 어떤 당 분자 하나가 다른 당 분자 하나와 결합된 것이다.
상업적 또는 생물학적 중요성을 지닌 몇 안 되는 이당류 중에서 중요한 것은 수크로오스·트레할로오스·락토오스·말토오스이다. 수크로오스(포도당과 프룩토오스로 구성)는 상업적으로 사탕수수나 사탕무를 부수어 물로 추출한 후 정제하고 결정화하여 얻는다. 농축된 액체로부터 침전한 순도가 떨어지는 결정을 누런설탕이라고 한다. 나머지 시럽형 물질은 최종 사탕수수 당밀 또는 폐당밀이라고 한다. 트레할로오스(2개의 포도당분자로 구성)는 많은 점에서 수크로오스와 비슷하지만 훨씬 적게 분포되어 있다. 이것은 어린 버섯과 여리고의 장미에 존재한다. 트레할로오스는 많은 곤충의 순환액에서도 발견되기 때문에 생물학적으로 상당히 중요하다.
락토오스(포도당과 갈락토오스로 구성)는 인간의 음식물에서 가장 흔하게 발견되는 당류 중의 하나이다. 모든 포유동물의 젖은 약 5%가 락토오스로 되어 있다. 말토오스는 천연에서 결합되지 않은 상태로 발견되지 않지만, 소화중에 녹말이 효소분해되어 나온 생성물이기 때문에 생물학적으로 중요하다. 말토오스는 2개의 포도당 분자로 구성되어 있지만, 트레할로오스와는 구조적으로 다르다.
다당류, 즉 글리칸류는 여러 방식으로 분류될 수 있다. 동종 다당류는 단 하나의 당류로 이루어진 다당류이다. 이것들은 단당류 단위체의 배열에 따라 곧은 사슬, 가지난 사슬 및 고리형으로 세분될 수 있다. 이종 다당류는 2종류 이상의 단당류를 포함하고 있다. 이것들의 분자도 직선이거나 가지난 구조일 수 있다. 가장 잘 알려진 다당류는 셀룰로오스와 녹말로 모두 동종 다당류이다. 식물의 기본 구조성분인 셀룰로오스는 3,000개 이상의 포도당 분자로 이루어진 커다란 선형 분자이다. 셀룰로오스는 종이와 직물 제조 등 매우 다양한 상업적 목적에 사용되며, 식물성 물질을 뜨거운 알칼리로 처리해서 만든다.
크실란은 셀룰로오스와 비슷한데, 크실로오스 단위체를 포함하고 있으며 식물 세포벽에서도 발견된다. 녹말이라는 용어는 포도당 단위체로 되어 있는 식물의 다당류 집단을 가리킨다. 대부분의 녹말은 2개의 성분, 즉 선형 성분(아밀로오스)과 가지친형 성분(아밀로펙틴)으로 이루어져 있다.
인간은 녹말을 개별 포도당 단위체로 분해시킨 후에 이용하는데, 우선 침에 들어 있는 아밀라아제의 작용으로 말토오스가 되며, 이것은 장벽을 통해 흡수되는 동안 포도당으로 가수분해된다. 또다른 중요한 동종 다당류는 글리코겐으로 모든 동물조직에서 발견되며 동물의 탄수화물을 저장하는 기본 형태이다. 글리코겐은 포도당 단위체로 되어 있으며, 녹말과 닮았지만 더 많은 가지가 나 있다. 갈락토오스나 갈락투론산(예를 들면 펙틴과 한천)으로 이루어져 있는 다당류는 겔을 만들 수 있기 때문에 중요하다. 펙틴류는 상업적으로 젤리와 잼 제조에 사용된다. 한천은 생물연구용 미생물의 배지 및 제과산업에서 겔합제로 사용된다.
4. 아밀라아제 [amylase]
수천 개의 포도당(글루코오스) 분자로 이루어진 녹말분자를 가수분해하여 포도당 두 분자가 결합된 말토오스 분자로 만드는 과정을 촉매하는 효소의 총칭.
아밀라아제는 α와 β의 2종류가 있다. 그들은 녹말분자의 결합을 분해하는 방식이 서로 다르다.
α-아밀라아제는 생물체에 널리 존재한다. 사람과 다른 여러 포유류의 소화계에서 프티알린이라고 불리는 α-아밀라아제는 침샘에서 만들어진다. 아밀롭신은 췌장에서 소장으로 분비되는데, 사람의 프티알린과 아밀롭신을 분리한 결과 차이가 없음을 알게 되었다. 프티알린은 입에서 음식물과 섞여 녹말에 작용한다. 음식물이 입 속에 머무르는 시간은 아주 짧지만 프티알린을 비활성화시키는 위액이 음식물과 섞일 때까지 프티알린은 위 속에서 몇 시간 동안 계속 작용한다. 프티알린의 소화작용은 위 속에 있는 산의 양, 위에 내용물이 머무는 시간, 내용물이 산과 섞이는 정도에 따라 다르다.
적절한 조건에서는 섭취된 녹말의 50%가량이 프티알린에 의해 위에서 말토오스로 분해된다. 음식물이 소장으로 들어가면 남아 있던 녹말분자가 아밀롭신에 의해 말토오스로 분해되며, 녹말은 담즙이 분비되는 소장의 시작부위인 십이지장에서 대부분 소화된다. 처음에 말토오스로 분해된 녹말은 다시 장벽을 통해 빨리 흡수되는 포도당분자로 분해된다. 말토오스 분자가 십이지장 벽에 있는 세포로 가면 이 세포들이 분비하는 효소로 말토오스가 포도당으로 분해되어 흡수된다. 때때로 아밀라아제라고도 하지만 흔히 이런 장효소를 말타아제라고 한다.
β-아밀라아제들은 효모·곰팡이·세균·식물들, 특히 씨에 존재하는데, 직물에서 녹말 크기만한 물질을 제거하고, 곡물을 발효당으로 전환시키는 데 사용하는 디아스타아제라는 혼합된 녹말효소의 기본 요소이다.
5. 혐기성
산소가 없는 곳에서 생육하는 세균. 파상풍균, 젖산균 따위가 있다.
6. 호기성
산소가 있는 곳에서 정상적으로 자라는 세균. 고초균, 아세트산균, 결핵균 따위의 대부분의 세균이 이에 속한다.
7. 사료분야에서 주로 사용되는 섬유소분해균
섬유소(纖維素)를 분해(分解)하여 번식(繁殖)하는 세균(細菌)ㆍ사상균(絲狀菌) 등(等)의 미생물(微生物). 진정(眞正) 세균(細菌)ㆍ점질(粘質) 세균(細菌)ㆍ방선균(放線菌)ㆍ사상균(絲狀菌)ㆍ담자균(擔子菌) 따위가 있음.
산림(山林)이나 밭의 흙에는 사상균(絲狀菌)과 세균(細菌)에 속(屬)하는 것이 많고, 논ㆍ하수(下水) 또는 초식 동물(動物)의 소화관(消化管) 속에는 세균(細菌) 특(特)히 혐기성(嫌氣性) 세균(細菌)에 속(屬)하는 것이 많음
1) yeast 효모균
낭자균(曩者菌) 중(中) 효모균과(酵母菌科)에 딸린 한 무리의 균류(菌類). 엽록소(葉綠素)가 없는 단세로포 된 균류(菌類)로 보통(普通) 둥근 모양이거나 길둥근 모양이며 그 종류(種類)가 많음. 출아법과 내생(內生) 포자(胞子) 생성법(生成法)에 의(依)해 번식(繁殖)함.
찌마아제(zymase)라는 효소(酵素)가 있어 발효(醱酵) 작용(作用)을 하여 술이나 빵을 만드는 데 많이 쓰임.
양모(釀母). 뜸팡이. 주모균(酒母菌). 효모(酵母) 우수한 단백질의 급원으로 제빵, 발효과정에 널리 사용되거나, 맥주의 원료로 맥아즙의 당분을 분해하고 알코올과 탄산가스를 만드는 작용을 하는 미생물.
효모 [yeast, 酵母]
대부분 자낭균강(子囊菌綱 Ascomycetes)에 속하며, 소수만이 담자균강(擔子菌綱 Basidiomycetes)에 속한다. 자낭균강에 속하는 효모는 일반적으로 빵·맥주·포도주를 생산하는 빵효모(Saccharomyces cereviseae)의 변종이다. 효모는 출아에 의해 무성생식한다. 작은 혹이 모(母)세포로부터 돌출하여 커지고 성숙하여 분리된다. 소수의 효모는 모세포가 2개의 동일한 딸세포로 나누어지는 분열에 의해 증식한다. 어떤 효모는 사람이나 다른 동물들에 나타나는 여러 가지 질병의 병원체가 되는데, 이러한 것에는 아구창 칸디다(Candida albicans)·히스토플라스마속(─屬 Histoplasma), 분아균속(Blastomyces) 등이 있다. 야생효모의 한 속인 토룰라속(Torula)은 불완전균으로 유성포자를 형성하지 않는다.
식품제조시 효모는 발효와 부풀리기에 이용된다. 효모는 당(糖)을 먹고 알코올과 이산화탄소를 내는데, 맥주·포도주 제조에는 알코올이, 제빵산업에는 이산화탄소가 각각 원하는 산물이다. 발포성 포도주와 맥주는 완성된 음료에 이산화탄소도 어느 정도 함유한다. 빵을 만들 때 나오는 알코올은 반죽을 익힐 때 빠져나간다.
포도주의 발효는 포도원에 자생하는 효모에 의해 시작되지만, 산업적으로 이용되는 효모가 알코올 발효 능력이 훨씬 우수하다. 효모는 단백질이 50% 이상이며, 비타민 B1과 B2, 니코틴산, 엽산(폴산)의 풍부한 공급원이다. 양조효모는 흔히 비타민 보충제로서 복용되기도 한다. 상업적으로 효모를 생산할 때는 선택된 균주를 당밀·무기염·암모니아를 첨가한 용액에서 키운다. 효모가 성장을 멈추었을 때 영양액에서 분리하여 씻어낸 후 포장한다. 제빵용 효모는 녹말을 섞은 압축된 덩어리나 옥수수가루가 섞인 건조된 과립형태로 판매한다.
2) Lactobacillus [유<젖>산간균, 乳酸桿菌]
젖산균과(─酸菌科 Lactobacillaceae)에 속하는 간균의 한 속.
스타필로코쿠스 : 전형적인 세균의 배양:여성의 질에서 배양된 호기성(好氣性) 세균인 젖산간균속(Lactobacillus, 큰 콜로니)과 통성혐기성균(通性嫌氣性菌)인 스타필로코쿠스 알부스(Staphylococcus albus, 작은 콜로니), 11배 확대
동물의 사료, 사일리지, 거름, 우유 및 유제품에 널리 분포한다. 대표 종(種)인 락토바실루스 델브루엑키이(Lactobacillus delbrueckii)는 그람 양성이며, 포자를 형성하지 않는 간균으로 지름이 0.5~0.8㎛(마이크로미터 : 1㎛〓10-6m)이고, 길이가 2~9㎛이다.불가리아젖산간균(L.bulgaricus)과 호산성젖산간균(L.aci- dophilus) 같은 젖산간균속의 여러 세균들은 우유를 발효시켜 불가리아 우유, 아시도필루스 밀크, 요구르트, 케퍼 같은 제품을 만드는 데 상업적으로 이용된다.
젖산간균(L. lactis), 불가리아젖산간균, 락토바실루스 헬베티쿠스(L. helveticus)는 치즈 제조의 초기단계에서 우유를 응고시키는 데 사용되는 다양한 세균들이다. 불가리아젖산간균 또한 유장(乳漿)으로부터 젖산을 만드는 데 상업적으로 이용된다. 젖산간균들을 이용한 상업적 조제품들은 항생제 치료 후 장내세균의 불균형을 정상으로 회복시키는 데 이용된다.
3) Bacillus [간균 : 바실러스]
식품의 부패와 관련된 고온 미생물의 1종류. 대부분의 그람 양성, 호기성, 포자 형성균 등을 포함하는 Eubacteriales목 Bacillaceae과 미생물.
간균과(桿菌科 Bacillaceae)에 속하는 막대 모양을 한 세균의 속(屬).
간균속 메가테리움
대장균
흙이나 물에 살고 있으며, 탄저균(Bacillus anthracis)이나 바실루스 투링기엔시스(B. thuringiensis) 같은 몇몇 종(種)을 빼고는 인간이나 동물에게 해를 주지 않는다. 모든 간균은 미생물학적으로 그람음성균으로 분류하며 휴면세포(休眠細胞)나 내생포자(內生胞子)를 만들 수 있다. 크기가 가장 큰 종(種)은 지름이 약 2㎛(마이크로미터:1㎛=10-6m)이고 길이가 7㎛로서 보통 사슬 모양을 이룬다. 내생포자처럼 열·화학물질·햇빛에 대한 저항력이 있고 거의 어느 곳에나 있는 먼지 입자들 속에 들어 있다. 간균이라는 용어는 일반적으로 원통 모양이나 막대 모양을 하고 있는 모든 세균에 적용된다.
흙 속에 많이 있는 세레우스균(B. cereus)은 흔히 통조림식품들을 부패시키고, 역시 널리 퍼져 있는 고초균(B. subtilis)은 실험실에서 배양액을 오염시키며 인간의 피부에서도 흔히 볼 수 있다. 병을 일으키는 병원체로 잘 알려진 것으로는 사람과 가축에게 탄저병 을 일으키는 탄저균과 식물에 해를 끼치는 털벌레에게 특효가 있어 상업적인 살충제로 이용되는 바실루스 투링기엔시스가 있다. 의학에서는 고초균에서 생성되는 박시트레신과 바실루스 폴리믹사(B. polymyxa)의 폴리믹신B를 항생제로 사용한다.
4) Aspergillus [누룩곰팡이속, 아스페르길루스속]
누룩곰팡이, 검정곰팡이 등을 포함하는 자낭균아문에 속하는 1군.
불완전균류(不完全菌類 Deuteromycetes)에 속하는 한 속.
누룩곰팡이속
여러 가지 병원균을 포함한다. 이들 중 유성생식기간을 거치는 종들은 유로티아목(─目 Eurotiales)으로 분류한다. 음식물이 썩을 때 생기는 검은 곰팡이는 흑색국균(A. niger)이며 아스페르길루스 플라부스(A. flavus), 아스페르길루스 푸미가투스(A. fumigatus)와 더불어 사람에게 아스페르길루스증을 일으킨다. 누룩곰팡이(A. oryzae)는 청주를 발효시키는 데, 아스페르길루스 웬티이(A. wentii)는 대두(大豆)를 가공하는 데 쓰인다. 자낭균류(Ascomycetes)에 속하는 에메리켈라속(Emericella)·유로티움속(Eurotium)·사르토르야속(Sartorya) 3속은 누룩곰팡이형 분생자(分生子:무성생식으로 번식하는 포자)를 만든다.